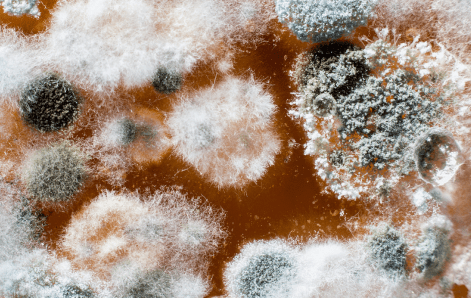
hongos_caso1_detalle

Casos de Éxito
Incremento de Vida de Anaquel en Queso fresco & Crema con uso de
Extracil
Introducción
Con la finalidad de evitar que la imagen de marca se fuera deteriorando en mayor medida, una destacada empresa
de
productos lácteos y derivados optó por considerar alternativas distintas de conservadores, esto con la
intención de
evitar rechazos por reducción de vida útil de sus productos debido al crecimiento microbiano.
Se logró un incremento de 18 a 36 días de vida útil con el uso de Extracil, lo que representó la
posibilidad de
expandirse a nuevos mercados y sentó las bases para un crecimiento sostenible.

Crecimiento bacteriano en superficie de Queso fresco
Acercamiento de hongos y bacterias en superficie de queso

Inhibición de crecimiento microbiano con Extracil
Implementación & Solución
Se llevó a cabo un análisis exhaustivo del problema y adaptamos la solución a las necesidades específicas
durante un
periodo de un mes, con soporte técnico y monitoreo por parte de nuestro equipo técnico. Nuestra
colaboración sigue
prosperando, con soporte continuo y futuros proyectos en desarrollo.
Extracil es un conservador de última generación diseñado para incrementar vida de anaquel en productos
lácteos con
alto porcentaje de humedad, principalmente queso fresco y crema. Es un biocida de gran efectividad que inhibe
el
desarrollo de bacterias, hongos y levaduras, especialmente creado para lograr un efecto prolongado en el
control de
microorganismos responsables de indicios del deterioro, lo que permite mantener las características
organolépticas
óptimas y por consiguiente mayor aceptación por el consumidor.
Extracil garantiza la eficacia con una aplicación mínima, reduciendo costo y dosis de aplicación para su
optimización.
¿Interesado en lograr resultados similares?
Contáctenos hoy para aprender cómo nuestras soluciones innovadoras pueden
transformar su negocio.
